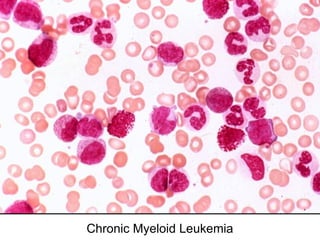
Chronic Myeloid Leukemia
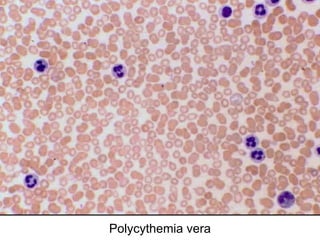
Polycythemia vera

The document provides an extensive overview of hematopoietic malignancies, particularly focusing on leukemias and lymphomas, and their classifications based on cell type and disease progression. It details the different forms of acute myeloid leukemia (AML), chronic myeloid leukemia (CML), and associated risk factors, genetic abnormalities, and clinical features. Additionally, it outlines laboratory findings essential for diagnosis and the pathology of these hematological disorders.